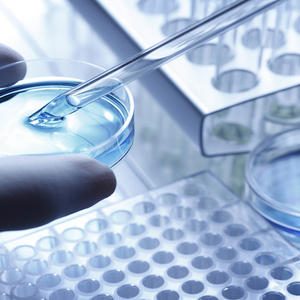

记者 |
编辑 | 任悠悠
药明生物(2269.HK)10月16日宣布其抗体偶联药物(Antibody-Drug Conjugates, ADC)原液和制剂厂DP3正式投入GMP商业化生产,成为全球为数不多的提供从抗体和抗体偶联药物原液到制剂一站式服务的企业。同时,药明生物与浙江医药(600216 SH)子公司新码生物达成深度战略合作,进一步支持新码生物的创新抗体偶联药物ARX788的Ⅲ期临床研究及大规模商业化生产。
双方的合作事实上从2013年就已开始,药明生物作为CMO为ARX788提供从工艺开发、放大到新药临床试验样品生产的全方位一体化研发服务,并支持该项目成功通过澳大利亚、新西兰、美国和中国的新药临床试验申请(IND)。项目ARX788还未完成Ⅰ临床试验,同时正在和CDE申报Ⅱ-Ⅲ期临床。
新码生物董事长兼总经理梁学军对界面新闻表示,虽然之前公司方面也研究过自主建厂生产,但综合各方面考虑后,最终决定继续与药明生物开展进行后续的产品商业化生产。
药明生物将为ARX788提供偶联原液和制剂成品Ⅲ期临床样品研制,工艺表征及验证研究,以及大规模商业化生产等技术服务。
抗体偶联药物也是国内目前热门领域之一,不过虽然技术和理念都已有多年,但目前全球也仅有5个ADC药物上市。梁学军介绍称,ADC在技术上其实难度很大,目前上市的药物实际上都是ADC混合物,其小分子偶联量与偶联的位置实际上并没有那么确定。这就会导致ADC药物会无法实现设想一样的高效率。而位置精准,定点释放则正是ADC药物的最主要优势。

梁学军介绍,除了偶联量与偶联的位置外,ARX788还在毒性上做了较好的控制。ADC药物的毒性主要有小分子脱落在血液里导致的毒性与靶点毒性两大类,ARX788已经完全解决了第一个问题,做到了偶联不会断裂;而在靶点毒性上,ARX788会在杀死癌细胞后会释放毒素,毒素不跨细胞膜,不会杀死别的细胞。
ADC药物同时也具有很大生产难度,药明生物首席执行官陈智胜介绍,目前全球ADC药物的CDMO产能不到一吨,且供应链复杂,一般是在中国生产小分子、欧洲生产抗体、美国进行偶联。DP3投产后ADC偶联原液年产能可达100千克,灌装冻干制剂年产能可达50万瓶。
值得注意的是,浙江医药也是为数不多的正在进行生物药研发的国内传统上市药企。梁学军表示,实际上从2000年开始就不断有人给浙江医药推荐一些生物大分子项目,但公司一直对项目的核心竞争力和产生的市场优势比较看重,最终看了很多后选中了这款ADC药物。
可以看出,与创新药企们通用的“VIC”模式相比,浙江医药占了IP和CDMO两点,而在项目选择上也会相对更保守稳妥。
在生物药上,除去恒瑞外,海正药业也是另一家布局早、品种多的传统药企,于2003就已开始启动生物药业务,旗下海正博锐目前已在自免疫和肿瘤治疗领域建立了丰富的生物药产品管线,已实现安佰诺®(注射用重组人II型肿瘤坏死因子受体-抗体融合蛋白)的规模化生产及销售,阿达木单抗生物类似物有望在今年年底或明年获批上市。
但近几年的内外动荡也对海正药业的生物药业务产生了不利影响,今年9月海正最终选择出让控股权,与私募机构太盟达成38.28亿元转让协议,出让海正博锐58%的股权,而据悉海正博锐后续将进行独立融资上市。此外,步长制药也在2018年下半年宣布向生物药转型,并发布了三十多个生物药研发管线,华海药业等也在生物药上有布局。